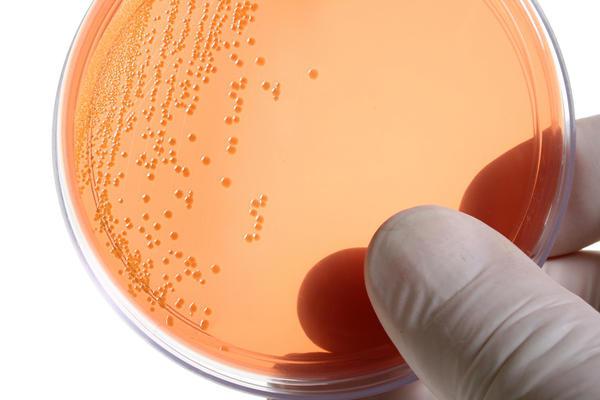

Самым распространенным заболеванием, передающимся половым путем, является хламидиоз. Лечение у женщин осложняется отсутствием выраженной симптоматики во многих случаях. Тем временем болезнь прогрессирует, развиваются осложнения. Статистика располагает данными, что ежегодно заражается свыше 140 миллионов человек. Чем вызвана болезнь, ее симптомы, возможные осложнения и какое существует эффективное лечение хламидиоза у женщин — рассмотрим в этой статье.
Что такое хламидиоз?
Хламидиозы – это целый ряд заболеваний, вызванных различными видами бактерии Chlamydia. Эти микроорганизмы становятся причиной заболеваний кожи, пневмонии и других болезней органов дыхания. Один из видов хламидий, а именно Chlamydia trahomatis, способствует возникновению урогенитального хламидиоза.
По строению микроорганизмы относятся к бактериям, но имеют особенность, присущую вирусам — паразитировать внутри клетки хозяина. Цикл заражения и проникновения хламидии в клетку составляет не более 2 суток. Именно в этот период микроорганизмы наиболее чувствительны к медицинским препаратам и ультрафиолету.
Но обычно на данном этапе не проводится лечение хламидиоза у женщин, препараты не принимаются, так как зачастую инфицированный человек не догадывается о заболевании из-за отсутствия симптомов. Тем временем бактерия размножается и появляются новые очаги поражения. Инкубационный период хламидиоза составляет до месяца в зависимости от иммунитета человека.
Пути инфицирования
Генитальный хламидиоз передается половым путем. Оральные контрацептивы и прерванный половой акт не могут защитить от инфицирования. Заражение происходит в 70% случаев при незащищенных интимных отношениях с партнером – носителем бактерии.
Хламидиоз передается от зараженной матери к новорожденному ребенку как внутриутробно, так и в процессе родовой деятельности. В медицинской науке возникают споры по поводу возможности передачи бактерии бытовым путем через общие средства личной гигиены и белье. Известно, что хламидии могут существовать во внешней среде до 2 дней. Погибают они только при обработке высокой температурой. Но какова вероятность заражения человека в таком случае – единого мнения не существует.
Формы заболевания
В медицине различают две формы хламидиоза в зависимости от степени поражения и длительности заболевания. Каждая из них имеет свою симптоматику и индивидуальную схему лечения. Классификация следующая:
- Свежая форма поражает нижнюю часть мочеполовой системы. Длительность заболевания до 2 месяцев.
- Когда бактерии распространяются на нижние отделы мочевыводящих путей и длительность их жизненных циклов свыше 2 месяцев, то врачи ставят диагноз «хронический хламидиоз». Лечение у женщин в таком случае предполагает дополнительные, часто комбинированные препараты антибактериального действия.
Хламидиоз у женщин: симптомы, лечение
Медицинская статистика утверждает, что в 67% инфицирования хламидиозом болезнь протекает абсолютно бессимптомно. В таком случае заболевание проявляет себя только в стадии хронического течения и развития осложнений с соответствующей симптоматикой. Чаще всего выраженные симптомы появляются только при запущенной хронической стадии развития хламидиоза и проявляются следующим образом:
- жжение в мочеиспускательном канале и влагалище;
- зуд половых органов;
- мутные с неприятным запахом выделения;
- болевые ощущения во время мочеиспускания;
- тянущая боль в области низа живота;
- неприятные ощущения во время полового акта;
- кровянистые выделения посередине менструального цикла;
- повышенная температура тела;
- нарушение менструального цикла.
Причины возникновения хламидиоза
Причинами масштабного распространения хламидиоза является недостаточная информированность общества о проблеме, особенно среди подростков. Мало кто знает, как происходит лечение хламидиоза у женщин. Препараты, необходимые для борьбы с заболеванием, тем временем, наносят дополнительный вред здоровью молодому организму, достаточно агрессивно воздействуя на него и имея ряд побочных эффектов.
Способствуют заражению бактерией: раннее начало половой жизни, беспорядочная смена партнеров, незащищенный презервативом половой акт.
Чем опасен для женщины
Напрашивается вопрос о том, что же такого страшного в хламидиозе, если в большинстве случаев болезнь не проявляет себя никакими болевыми симптомами? Ответ однозначен — заболевание опасно развитием серьезных осложнений. При отсутствии необходимого лечения хламидии могут поражать репродуктивные органы и способствовать возникновению таких патологических процессов:
- цервицит или воспаление шейки матки;
- патологические процессы в матке, яичниках, фаллопиевых трубах;
- спаечные процессы в органах малого таза;
- эндометрит – эндометрия матки;
- цистит и уретрит;
- как следствие осложнений — бесплодие.
Кроме этого хламидиоз снижает защитные силы организма и поэтому к нему часто присоединяются другие бактериальные инфекции репродуктивных органов. Организм не вырабатывает антитела к паразитам, поэтому возможно многократное повторное заражение и лечение хламидиоза у женщин. Схема приема препаратов при этом должна быть составлена с учетом применения предыдущих лекарственных средств и реакций на них организма.
Опасность хламидиоза во время беременности
Крайне опасен хламидиоз у беременных женщин. Лечение осложняется невозможностью приема пациенткой целого ряда необходимых медикаментов, так как большинство из них могут крайне негативно отразиться на развитии плода. Бессимптомное протекание заболевания, а соответственно, позднее его обнаружение и несвоевременное назначение лечения могут привести к осложнению или прекращению беременности: лихорадке, многоводию, неразвивающейся беременности, разрыву плодного пузыря, выкидышу или преждевременным родам. Возрастает вероятность развития внематочной беременности, если зачатие произошло при наличии инфекции в организме женщины. В 30% случаев заражению подвергается плод внутриутробно, и в 40% инфицируется ребенок во время прохождения по родовым путям.
Чем опасен для ребенка
Большая вероятность заражения ребенка во время беременности инфицированной матери. Болезнь опасна осложнениями в родах, что неблагоприятно отразится на состоянии малыша. При попадании паразитов в организм ребенка развиваются такие заболевания, как назофарингит, конъюнктивит, хламидийная пневмония, вульвовагинит и уретрит.
Диагностика хламидиоза
Заподозрить наличие инфекции может врач-гинеколог во время общего осмотра с помощью зеркал. Он сможет обнаружить симптомы, характерные для большинства заболеваний половой системы: воспалительные процессы, участки эрозии, большое количество выделений, соответствующую их консистенцию, цвет и запах.
Для подтверждения диагноза и выявления причин патологических процессов специалист возьмет мазок из влагалища для бактериологического анализа. Выявить наличие хламидий общий мазок не может, но он определит другие инфекции, передающиеся половым путем, которые часто развиваются параллельно хламидиозу.
Анализ крови для определения антител к хламидиозу также не может с уверенностью подтвердить диагноз. Так как наличие или отсутствие антител не может достоверно свидетельствовать о наличии живой бактерии в организме.
ПЦР – диагностика проводится для определения ДНК хламидий. Материалом для анализа являются влагалищные выделения. Положительный результат анализа достоверно подтвердит наличие инфекции. Но в случае отрицательного, необходимы дополнительные исследования.
Бактериальный посев является самым достоверным способом обнаружения хламидиоза. Материал для анализа (выделения из влагалища) помещают в благоприятную для хламидий среду. Затем, через необходимое для роста и размножения бактерий время, под микроскопом определяют наличие или отсутствие таковых.
Методы лечения хламидиоза
Лечат болезнь общими и местными методами. Проводится основное лечение хламидиоза у женщин антибиотиками. Схема лечения разрабатывается врачом в индивидуальном порядке. При выборе антибактериального средства необходимо учесть следующие факторы:
- лекарство должно быстро и в необходимой концентрации проникать в пораженную хламидией клетку;
- длительность лечения препаратом составляет 6 жизненных циклов бактерии. Один цикл развития длится от 48 до 72 часов, т. е. курс лечения хламидиоза у женщин займет не менее 12 дней;
- заболевание должно быть вызвано чувствительными к антибиотикам штаммами паразита. Некоторые виды хламидий имеют устойчивость к антибактериальным препаратам;
- при выборе лекарственного средства необходимо учесть форму развития заболевания: свежая или хроническая;
- в зависимости от наличия дополнительных инфекций врач может назначить антибиотик широкого спектра действия или несколько препаратов одновременно;
- медикаментозное лечение должны проходить оба партнера.
Кроме антибактериальных средств, назначают иммуномоделирующие препараты, пробиотики, ферменты.
Схема лечения хламидиоза
При подтверждении диагноза необходимо назначить правильное лечение хламидиоза у женщин. Схема следующая:
1. Макролиды для лечения хламидиоза имеют наиболее высокую эффективность:
- препарат «Эритромицин»: 0.5 г 4 раза в сутки 2 недели;
- средство «Джозамицин»: 1 г разово, затем 0.5 г два раза в день 10 дней;
- лекарство «Спирамицин»: трижды в сутки по 3 млн МЕ 10 дней;
- препарат «Клацид»: дважны в день по 250 мг 14 дней.
2. Фторхинолоны применяют реже, так как многие виды бактерий устойчивы к данному типу антибиотиков:
- средство «Офлоксацин»: по таблетке дважды в сутки в течение 10 дней. При неэффективности врач может увеличить дозировку;
- лекартсво «Ломефлоксацин»: по 1 таблетки раз в сутки, 10 дней применяют при неосложненных формах хламидиоза;
- препарат «Пефлоксацин»: по 600 мг однократно 7 дней.
3. Антибиотик широкого спектра действия «Клиндамицин» принимают по 2 таблетки 4 раза в сутки курсом в 7 дней. С помощью данного препарата происходит эффективное лечение хламидиоза у женщин. Отзывы свидетельствуют о большинстве случаев полного излечения и минимальном количестве побочных реакций на лекарство.
Иммуномоделирующая терапия помогает организму укрепить силы для борьбы с инфекцией, когда проводится лечение хламидиоза у женщин. Препараты назначают следующие: средство «Циклоферон» курсом в 5 инъекций по назначенной схеме параллельно приему антибиотиков. И препарат «Неовир» из 7 инъекций по 250 мл через каждые 48 часов после курса антибиотиков.
Антибиотики крайне негативно отражаются на микрофлоре ЖКТ. Для профилактики развития заболеваний желудка назначают ферментные препараты и пробиотики: «Бифидумбактерин», «Лактобактерин», «Хлорелла», «Хилак–форте» и другие.
Местное лечение хламидиоза
Кроме общей терапии, гинеколог назначает и местное лечение хламидиоза у женщин. Свечи обладают противовоспалительными и антибактериальными свойствами. Используют и раствор димексида в виде тампонов, антибактериальные гели и крема, спринцевания. Для восстановления сил организма врач назначит комплекс поливитаминов, например «Супрадин». Во время лечения инфекции необходимо воздержаться от полового акта или использовать презерватив.
Физиотерапевтические процедуры
При лечении хламидиоза, особенно в хронической форме, эффективными дополнительными метода лечения являются методы физиотерапии:
- низкочастотным ультразвуком;
- местный лазерофорез;
- электрофорез;
- УФОК.
Лечение хронического хламидиоза
Если врачом поставлен диагноз «хронический хламидиоз», у женщин лечение предполагает следующую схему:
- Инъекции препаратов «Неовир» или «Циклоферон» через день 7 раз.
- Средство «Ровамицин» начинают принимать по 3 млн МЕ трижды в сутки после третьей инъекции циклоферона. Курс лечения составляет 14 дней.
- Препарат «Дифлюкан» по 1 капсуле на 7 й и 14-й день лечения основного антибиотика.
- Витаминные комплексы.
- Процедуры физиотерапии по показаниям.
Лечение во время беременности
Нередким заболеванием во время беременности является хламидиоз. Лечение у женщин, находящихся в положении, осложнено подбором препаратов, которые окажут наименьший вред плоду, излечив при этом мать. Врач должен внимательно изучить конкретный случай инфицирования и в индивидуальном порядке разработать схему лечения. Чаще всего применяют такие методы борьбы с паразитом:
- Терапия антибиотиками по назначению врача: препараты «Эритромецин», «Ровамицин», «Сумамед».
- Иммуномоделирующая терапия с помощью таких препаратов, свечей, в состав которых входят такие вещества, как миелопид, нитрата эконазол или интерферон.
- Пробиотические препараты в виде местных свечей и пероральных средств.
Подтверждение излечения
Так как хламидиоз редко проявляется выраженными симптомами и по их отсутствию никак нельзя судить об эффективном лечении заболевания, после прохождения медикаментозного курса борьбы с инфекцией обязательно необходимо провести контрольные анализы в несколько этапов и разными методами:
- Сразу после завершения курса лечения нужно сдать анализы на культурный посев хламидий. Повторный анализ нужно пройти через месяц, желательно в той же лаборатории. Только после результатов последнего посева можно с уверенностью говорить об излеченности женщины от хламидиоза.
- Анализ ПИФ или прямую иммунофлюорестенцию проводят не раньше 1,5 месяца после завершения курса лечения.
Профилактика хламидиоза
Серьезными осложнениями чреват хламидиоз. Лечение у женщин проводится антибактериальными препаратами, оказывающими неблагоприятное воздействие на различные внутренние органы. Избежать многих проблем со здоровьем помогут профилактические методы, а именно: ответственное отношение к собственному здоровью, которое проявляется в исключении беспорядочной половой жизни и прохождении, использовании барьерных методов контрацепции и регулярных медицинских осмотров. Для предотвращения осложнений во время беременности и во время ее планирования необходимо сдать анализ на хламидиоз и другие инфекции, передающиеся половым путем.
Хламидиоз коварен бессимптомностью и быстротой распространения. Поэтому отсутствие лечения или самостоятельные попытки борьбы с инфекцией могут привести к непредвиденным последствиям и серьезному нарушению состояния здоровья зараженного человека и его партнера. Обращение к врачу поможет предотвратить развитие осложнений и преодолеть болезнь.
Хламидиоз — это серьезное венерическое заболевание, которое рецидивирует при неправильном лечении. Но чем лечить хламидиоз, чтобы полностью от него избавиться? Рассмотрим детально все эффективные методики лечения.
Выбор лекарственного препарата
Хламидиоз — это инфекция, которая вызывает активное воспаление в мочеполовых органах. Для борьбы с этим осложнением назначаются различные препараты разных групп. Курс лечения хламидиоза назначается индивидуально каждому пациенту на основе индивидуальных особенностей его организма.
Также обязательно назначается курс препаратов для укрепления иммунной системы. Если иммунная система не будет влиять на инфекцию, то лечение препаратами будет бесполезным.
Для лечения хламидиоза назначаются такие группы препаратов:
- интерфероны (Неовир, Амиксин, Циклоферон и т.д.);
- иммуномодуляторы (Тималин, Деринат, Полиоксидоний);
- системная энзимотерапия (Трипсин, Флогэнзим, Вобэнзим, Лонгидаза) — это смеси животного и растительного происхождения, в состав которых входят специальные ферменты, стимулирующие иммунную систему;
- гепатопротекторы (Фосфоглив, Легалон, Карсил) — препараты, которые защищают печень от воздействия токсинов;
- пробиотики (Энтерол, Лактобактерин, Бификол) — препараты, которые нормализуют работу кишечника, восстанавливая его микрофлору.
Значение антибиотиков
Для того чтобы избавиться от хламидий, необходимо использовать антибиотики. Это самый важный препарат при лечении хламидиоза. При хронической форме заболевания используется несколько видов антибиотиков, потому что хламидии имеют свойство мутировать, привыкая к ранее применяемым лекарствам.
Препараты выбираются лечащим врачом лишь на основе исследования хламидий на предмет чувствительности того или иного препарата. Среди наиболее эффективных препаратов при лечении хламидиоза можно выделить такие: Доксициклин, Певлоксацин, Вильпрофен, Эритромицин, Левофлоксацин.
Как проходит лечение?
Схема лечения хламидиоза зависит от его формы. Если хламидиоз выявлен на ранней стадии или проявляется в вялотекущей форме, то схема лечения состоит из таких этапов:
- Подготовительный. Он занимает неделю. В этот период назначаются препараты для усиления иммунной системы. Назначаются микроклизмы и ванночки с раствором Хлоргексидина.
- Базисный. Этот этап занимает 10-14 дней. В этот период назначаются антибиотики и противогрибковые препараты.
- Восстановительный. Длится около 14 дней. В этот период назначаются препараты, которые помогают восстановить микрофлору кишечника и нормальное функционирование печени.
Сложнее проходит лечение хронического хламидиоза, которой, как правило, сопровождается воспалением внутренних половых органов человека. В этом случае применяется следующая схема лечения:
- Назначаются антибиотики, витаминные комплексы, антиоксиданты и препараты, стимулирующие иммунную систему. На седьмой день лечения в курс лечения вводятся противогрибковые средства и энзимы.
- Через две недели вводятся гипатопротекторы, назначаются специальные физиотерапевтические процедуры (ультразвук и лазеромагнитные волны).
Лечение хламидиоза может быть успешным лишь в том случае, если используются только активные препараты, которые могут проникать в клетки хламидий; правильно определена форма заболевания и выявлены все очаги поражения; курс лечения должен длиться не менее трех недель, что позволит охватить несколько циклов жизнедеятельности хламидий и уничтожить всех возбудителей.
Применение народных средств
Хламидиоз — это заболевание, которое сопровождает человека многие сотни лет. За это время народными целителями было выработано несколько эффективных рецептов.
Спринцевание половых органов отваром гривастой караганы. Для приготовления отвара необходимо одну столовую ложку залить 200 миллилитрами горячей воды. Далее смесь настаивают не меньше получаса, после чего процеживают. Отвар набирается в небольшой шприц и вводится во влагалище или уретру.
Для укрепление иммунной системы употребляется сок лимонника или женьшеня, настойка эхинацеи или элеутерококка. Их разбавляют в 100 миллилитрах воды, в которую добавляют столько капель вещества, сколько больному лет.
Очень эффективно при хламидиозе помогает сбор трав: укроп (одна чайная ложка), лист кипрея (три чайные ложки), ромашка (две чайные ложки), хмелевые шишки (две чайные ложки), душица (две чайные ложки), мята (две чайные ложки), цветки лабазника (две чайные ложки), корни синюхи (одна чайная ложка) и аира (две чайные ложки). Все травы тщательно измельчаются в кофемолке, после чего заливаются 500 миллилитрами кипятка. Смесь переливается в термос и настаивается 12 часов. Сбор необходимо принимать по 50 миллилитров четыре раза в день. Стоит отметить, что беременным женщинам эту смесь трав принимать запрещается.
Эффективно помогает спринцевание настойкой цветков календулы на спирте (крепостью не более 70 градусов).
Трава должна настаиваться 14 дней в темном месте в стеклянной посуде, которую следует встряхивать каждый день. Перед спринцеванием настойку разводят теплой водой в пропорции 1:10 (одна часть настойки).
Лечение народными средствами может использоваться лишь в виде дополнительных мер. Многие венерологи назначают народные средства одновременно с лекарственными препаратами, потому что они помогают больному легче перенести побочные эффекты препаратов.
Эффективность лечения хламидиоза зависит от своевременного обращения больного к врачу, который назначит правильную схему лечения. Но главное помнить, что хламидиоз передается половым путем, поэтому необходимо избегать случайных половых контактов.
Схема лечения хронического хламидиоза подбирается специалистом, исходя из основных проявлений болезни, интенсивности воспалительного процесса, результатов лабораторных исследований биоматериала. Она может быть неодинаковой для мужчин и женщин. Эффективный лечебный курс традиционно строится на применении препаратов различных групп, что позволяет получить максимально высокие результаты.
Какие препараты выбрать для лечения хронического хламидиоза
Часто хроническая форма хламидиоза поддается лечению сложнее острой. Потребуется длительный курс приема антибиотиков. Их назначает лечащий врач, исходя из многих особенностей организма пациента.
Самыми эффективными считаются препараты из группы макролидов. Предпочтение традиционно отдается:
- Азитромицину.
- Ровамицину.
- Спирамицину.
- Джозамицину.
- Кларитромицину.
- Эритромицину.
- Сумамеду.
Антибиотики тетрациклинового ряда и фторхинолоны применяются в качестве альтернативного лечения.
Для подбора наиболее подходящего препарат от хламидиоза потребуется проведение бактериологического посева, позволяющего определить чувствительность вируса к конкретным лекарствам. Базисная терапия занимает от 5 до 7 дней.
Часто одного курса антибиотикотерапии становится недостаточно. В большинстве случае проводятся еще 3-4 курса.
Помимо антибиотиков обязательными станут иммуномодуляторы, мультивитаминные комплексы, антиоксиданты, пирогенные препараты. На 6-8 дни схема лечения нередко дополняется приемом действенных противогрибковых и ферментных препаратов.
Минимальная длительность первого лечебного курса составляет 2 недели, после чего обязателен восстановительный этап. В этот период пациенту показаны гепатопротекторы, физиотерапевтические процедуры. В домашних условиях рекомендуется проводить микроклизмы, ванночки с хлоргексидином.
Особенностью лечения хронического хламидиоза является назначение пациентам высоких доз всех лекарств. В результате этого удается полностью очистить организм от хламидийной инфекции — болезнь отступает в 99% случаев.
Схема лечения у женщин
Общая схема лечения выглядит следующим образом:
- инъекции неовиром или циклофероном – 7 раз, с перерывами в 1 день;
- ровамицин – 3 млн МЕ трижды ежедневно (после 3-й инъекции с циклофероном);
- дифлюкан – по 1 капсуле на 7-е и 14-е сутки лечения основным препаратом.
При необходимости лечить хламидийную инфекцию у беременных женщин можно таким препаратом, как эритромицин. Терапия проводится не ранее наступления срока в 20 недель.
Существуют 2 схемы применения лекарственного средства у этой категории пациенток:
- 500 мг 4 раза в течение дня (длительность приема – 1 неделя).
- 250 мг четырежды в сутки (курс – 14 дней).
В борьбе с хроническим хламидиозом хороший эффект демонстрирует спирамицин. Назначается препарат в дозировке 3 млн МЕ троекратно в сутки. Продолжительность 1 курса – 7-10 дней.
Полному излечению от хронической формы хламидиоза, устранению неприятных симптомов и восстановлению организма способствует общеукрепляющая терапия. С этой целью применяются иммуномодуляторы (виферон, лаферон, герпферон), адаптогены (в виде настоек лекарственных растений), витаминно-минеральные комплексы, проводятся физпроцедуры по показаниям.
Дополнительным способом лечения хронического хламидиоза у пациентов обоих полов является энзимотерапия, подразумевающая применение специальных смесей с активными ферментами животного и растительного происхождения. Этот метод позволяет положительно воздействовать на весь организм, и обеспечить концентрацию антибактериальных препаратов в очагах инфекционного процесса.
Терапия хронического хламидиоза антибиотиками у женщин, включая беременных пациенток, чаще всего занимает от 3 до 6 месяцев.
Схема приема у мужчин
Принцип лечения хронической формы заболевания у мужчин во многом схож с терапией, проводимой у женщин. Для максимальной эффективности одновременно применяются несколько видов антибиотиков. Рассмотрим схему приема лекарственных препаратов.
| Виды препаратов | Дозировка и частота применения |
| Антибиотики | Азитромицин – первые 5 дней 500 мг внутривенно, далее – 1 таблетка по 500 мг дважды в сутки. |
Офлоксацин – день первый – 400 мг утром, 320 мг вечером, далее – 200 мг дважды в сутки (курс – 3 недели).
Иммуномодуляторы Полиоксидоний – 5 инъекций по 6 мг через день, затем дважды в неделю, всего – 10 уколов.
Виферон – 1 свеча дважды в сутки ректально на протяжении 10 дней, затем 1 свеча дважды в сутки однократно с 4-дневными перерывами (10 повторов).
Ликопид – 1 таблетка под язык дважды в сутки. После 10 дней приема – по 1 таблетке еще в течение 10 дней (через сутки).
Пирогенные препараты Пирогенал – по 1 инъекции каждые 2 дня (первая доза – 5 мкг, каждая последующая увеличивается).
В случае необходимости в схему лечения вносят изменения, а основной антибиотик заменяют вильпрафеном. Длительность приема этого лекарства составит от 10 дней до 1 месяца.
Дополнительно назначается курс пробиотиков для восстановления организма (бифидобактерина, лактобактерина, линекса). Одним из факторов, влияющих на лечение, является защита печени. Для ее поддержки показан курсовый прием гепабене, эссенциале форте. При нарушениях кишечного баланса, вызывающих проблемы с пищеварением, проводится коррекция состояния ферментными препаратами:
Важным условием лечения хламидийной инфекции станут соблюдение диеты и исключение алкоголя. Прием лекарственных средств проводится обоими половыми партнерами. В противном случае положительный прогноз избавления от болезни маловероятен.